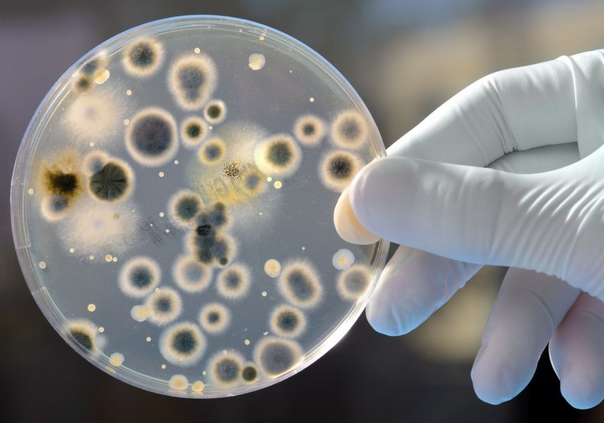

Dada uma função quadrática cuja fórmula é \(y=4x-x^2\text{,}\) acharemos os pontos atribuindo valores a x e usando a fórmula, vamos determinar os valores de y. Vamos usar para os valores de x, os inteiros -1 a 5.
\(x=-1 \Rightarrow y=4\cdot(-1)-(-1)^2=-4-1=-5 \therefore \)A=(-1,-5)
\(x=0 \Rightarrow y=4\cdot(0)-(0)^2=0-0=0 \therefore \)B=(0,0)
\(x=1 \Rightarrow y=4\cdot(1)-(1)^2=4-1=3 \therefore \)C=(1,3)
\(x=2 \Rightarrow y=4\cdot(2)-(2)^2=8-4=4 \therefore \)D=(2,4)
\(x=3 \Rightarrow y=4\cdot(3)-(3)^2=12-9=3 \therefore \)E=(3,4)
\(x=4 \Rightarrow y=4\cdot(4)-(4)^2=16-16=0 \therefore \)F=(4,0)
\(x=5 \Rightarrow y=4\cdot(5)-(5)^2=20-25=-5 \therefore \)G=(5,-5)






Fonte: 

Fonte:

(
(
(


